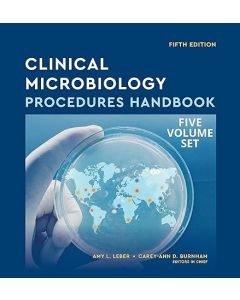
Clinical Microbiology Procedures Handbook, Multi-Volume, 5th Edition

Utilizamos cookies para melhorar a navegação dos nossos utilizadores. Para cumprir com a nova legislação de privacidade, precisamos de pedir o seu consentimento para continuar a usar cookies. Saiba mais.
Microbiologia / Parasitologia / Infeciologia
 Doenças Infecciosas em Cães e Gatos 4a ediçãoSpecial Price 238,50 € Regular Price 265,00 €
Doenças Infecciosas em Cães e Gatos 4a ediçãoSpecial Price 238,50 € Regular Price 265,00 € Murray's Basic Medical Microbiology, 2nd EditionSpecial Price 34,33 € Regular Price 38,15 €
Murray's Basic Medical Microbiology, 2nd EditionSpecial Price 34,33 € Regular Price 38,15 € Georgis' Parasitology for Veterinarians, 11th EditionSpecial Price 96,26 € Regular Price 106,95 €
Georgis' Parasitology for Veterinarians, 11th EditionSpecial Price 96,26 € Regular Price 106,95 € Greene's Infectious Diseases of the Dog and Cat, 5th EditionSpecial Price 171,71 € Regular Price 190,79 €
Greene's Infectious Diseases of the Dog and Cat, 5th EditionSpecial Price 171,71 € Regular Price 190,79 € Microbiologia Médica 9a ediçãoSpecial Price 188,89 € Regular Price 209,88 €
Microbiologia Médica 9a ediçãoSpecial Price 188,89 € Regular Price 209,88 € Veterinary Microbiology, 4th EditionSpecial Price 168,67 € Regular Price 187,41 €
Veterinary Microbiology, 4th EditionSpecial Price 168,67 € Regular Price 187,41 € Veterinary Parasitology 5yh editionSpecial Price 140,23 € Regular Price 155,81 €
Veterinary Parasitology 5yh editionSpecial Price 140,23 € Regular Price 155,81 € Atlas of Parasitological Diagnosis in Dogs and Cats. Volume II: EctoparasitesSpecial Price 64,21 € Regular Price 71,35 €
Atlas of Parasitological Diagnosis in Dogs and Cats. Volume II: EctoparasitesSpecial Price 64,21 € Regular Price 71,35 € Atlas de diagnóstico parasitológico del perro y el gato. Volumen II: EctoparásitosSpecial Price 64,21 € Regular Price 71,35 €
Atlas de diagnóstico parasitológico del perro y el gato. Volumen II: EctoparásitosSpecial Price 64,21 € Regular Price 71,35 € Principles and Practices of Canine and Feline Clinical Parasitic DiseasesSpecial Price 147,58 € Regular Price 163,98 €
Principles and Practices of Canine and Feline Clinical Parasitic DiseasesSpecial Price 147,58 € Regular Price 163,98 € Clinical Laboratory Management, 3rd EditionSpecial Price 224,09 € Regular Price 248,99 €
Clinical Laboratory Management, 3rd EditionSpecial Price 224,09 € Regular Price 248,99 € Clinical Microbiology Procedures Handbook, Multi-Volume, 5th EditionSpecial Price 424,43 € Regular Price 471,59 €
Clinical Microbiology Procedures Handbook, Multi-Volume, 5th EditionSpecial Price 424,43 € Regular Price 471,59 €